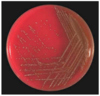

Presentation of Breathlessness, Fever, and Heart murmurs. What are differentials ?
Infective endocarditis, Pericardial disease, Myocarditis, Sepsis
What is infective endocarditis ?
Infection of the endothelium of the heart valves
-Life threatening - often diagnosed late
-Up to 25% mortality
-May be “acute” or “subacute”
Vegetations grown:

What are predisposing factors to infective endocarditis ?
Heart valve abnormality
-Calcification/sclerosis in elderly
-congenital heart disease (e.g. bicuspid aortic valve)
-post rheumatic fever
Prosthetic heart valve
People who inject drugs
Intravascular lines
How does endocarditis develop ?
1) Heart valve damaged
2) Turbulent blood flow over roughened endothelium
3) Platelets/fibrin deposited
4) Bacteraemia (may be very transient) e.g. from dental treatment in high- risk patients
5) Organisms settle in fibrin/platelet thrombi becoming a microbial vegetation
Which side of the heart is more commonly affected by infective endocarditis ?
Left side of heart more commonly affected (mitral and aortic valves)
-In IV drug users right side more likely to be affected
How can vegetations cause further issues ?
Infected vegetations are friable and break off, becoming lodged in the next capillary bed they encounter causing abscesses or haemorrhage - may be fatal. Lungs, brain etc.
How does acute infective endocarditis present and what causes it ?
Presents as overwhelming sepsis and cardiac failure
Usually due to aggressive (virulent) organisms such as Staphylococcus aureus
How does subacute infective endocarditis present and what causes it ?
Slow onset
Fever
Malaise
Weight loss
Tiredness
Breathlessness
What are roth spots ?
Non-specific red spots seen on the retina
-caused by infective endocaridits

What are Janeway lesions ?
Non-tender, small, erythematous or haemorrhagic or nodular lesions on the palm or sole caused by septic emboli
-Can be caused by infective endocarditis

What are Osler nodes ?
Painful, red, raised lesions found on the palms or sole caused by immune complex deposition
-Can be caused by infective endocarditis

How can a definitive infective endocarditis result be determined ?
Two major criteria, one major + three minor criteria, or all five minor criteria
Duke criteria
What are the microbiology major criteria for infective endocarditis ?
> 2 separate sets of blood cultures with typical organisms isolated
3 separate sets of blood cultures with non-typical organisms
Laboratory tests (pcr or IgG
Causes sustainced positive blood cultures; 1+ and 1- means not IE
What is bacteraemia ?
Blood is normally sterile, viable bacteria in the bloodstream cause bacteraemia
-Potentially life-threatening but not always significant
-If body’s response to infection is dysregulated and causes organ dysfunction, this is called sepsis
Used to be called septicaemia
Bacteria found in blood may not be the one causing any illness
What should be done for suspected IE before confirming results are obtained ?
Empiric treatment; best-guess
What is the difference between staph and streptococcus ?
Staphylococcus = Gram-positive cocci in clusters
Streptococcus = Gram positive cocci in chains
Gram positives are the big endocariditis ones

How can different staphylococci be distinguished ?
Coagulase test distinguishes Staphylococcus aureus from Coagulase-negative staphylococci (like Staphylococci epidermidis)
-Coagulase negatives are rarely virulent and seldom need antibiotics unless complicating factors exist e.g. metal/plastic in body or sustained + results
What is MALDI-TOF ?
Matrix Assisted Laser Desorption/Ionisation – Time Of Flight
-Alows for rapid organism identification and rapid determination of its susceptibility
How should blood cultures be used in IE?
Take 3 sets of blood culture taken
-If all are positive there is good evidence of continuing bacteraemia.
-If only one set taken and is positive might be a contaminant.
-Should be taken before any antibiotics
-If blood cultures negative, consider serology for additional organisms
(Sets taken over 30-60 mins)
Contaminant = bacteria added to sample during extraction; error
What are common bacteria causing native valve IE ?

What are unusual organisms which can cause IE ?
Not usually cultured organisms (PCR used)
-Bartonella, Coxiella burnetii (Q-fever), Chlamydia, Legionella, Mycoplasma, Brucella
Gram-negatives
-HACEK organisms; Haemophilus spp. , Aggregatibacter spp , Cardiobacterium, Eikenella sp., Kingella sp.
-Non HACEK gram negatives
-Hard to grow
Fungi
-Hard to treat here
What are examples of gram positive bacteria which cause IE ?
Staph A
Staph Epidermis
Viridans Group Streptococci
What is staph epidermis ?
Often a skin contaminant, but can infect prosthetic material e.g. ICED, prosthetic heart valves/joints, lines
-Most common coagulase-negative staphylococci
-Take more than one set of blood cultures to confirm significance
What are signs of subacute IE ?
Fever
New or changing heart murmur
Finger clubbing
Splinter haemorrhages
Splenomegaly
Roth spots, Janeway lesions, Osler nodes
Microscopic haematuria